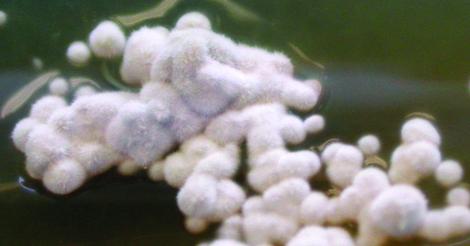
Culture of Onychocola canadensis

Onychocola canadensis
Onychocola canadensis is an uncommon cause of distal and lateral subungual or white superficial onychomycosis.
However, it may sometimes be present in an abnormal-appearing nail as an insignificant finding, not acting as a pathogen.
Culture of Onychocola canadensis.
RG-2 organism.
Morphologial description:
Colonies grow slowly and are velvety to lanose, white to yellowish, with a brownish reverse. Arthroconidia are cylindrical to broadly ellipsoidal, one to two-celled, hyaline to subhyaline, 4-16 x 2-5 µm in size, forming long chains. Older cultures may show broad, brown, rough-walled hyphae.

Arthroconidia of Onychocola canadensis.
Key features:
Slow growing, white, arthroconidial mould isolated from nails.
References:
- de Hoog, G.S., Guarro, J., Gene, J., et al. (2015) Atlas of Clinical Fungi (Version 4.1.2). Centraalbureau voor Schimmelcultures, Utrecht, The Netherlands.
- Gupta, A.K., Horgan-Bell, C.B. and Summerbell, R.C. (1998) Onychomycosis associated with Onychocola canadensis: ten case reports and a review of the literature. Journal of the American Academy of Dermatology, 39, 410-407.
- Kidd, S., Halliday, C., Ellis, D. (2023) Descriptions of Medical Fungi (4th edition). CABI.
- Sigler, L. and Congly, H. (1990) Toenail infection caused by Onychocola canadensis gen. et. sp. nov. Journal of Medical and Veterinary Mycology, 28, 405-417.
- Sigler, L., Abbott, S.P. and Woodgyer, A.J. (1994) New records of nail and skin infection due to Onychocola canadensis and description of its teleomorph Arachnomyces nodosetosus sp. nov. Journal of Medical and Veterinary Mycology, 32, 275-285.
